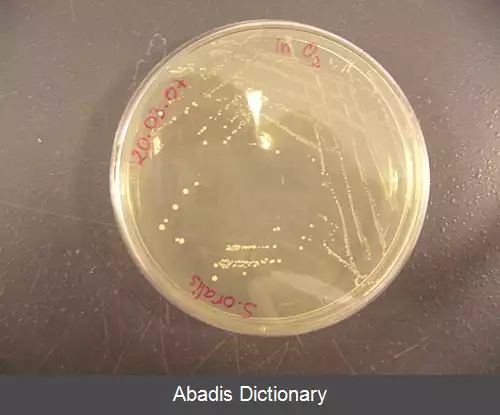
عکس استرپتوکوک اورالیس

استرپتوکوک اورالیس ( Streptococcus oralis ) ، یکی از گونه های همزیست استرپتوکوک در دهان است. این باکتری در گروه استرپتوکوک میتیس نیز طبقه بندی شده است. استرپتوکوک اورالیس، بیماریزای فرصت طلب است. سویه های استرپتوکوک اورالیس، آنزیم های نورامینیداز و IgA پروتئاز تولید می کنند و نمی توانند به آلفا - آمیلاز متصل شوند[ ۱] .
این نوشته برگرفته از سایت ویکی پدیا می باشد، اگر نادرست یا توهین آمیز است، لطفا گزارش دهید: گزارش تخلف
wiki: استرپتوکوک اورالیس
